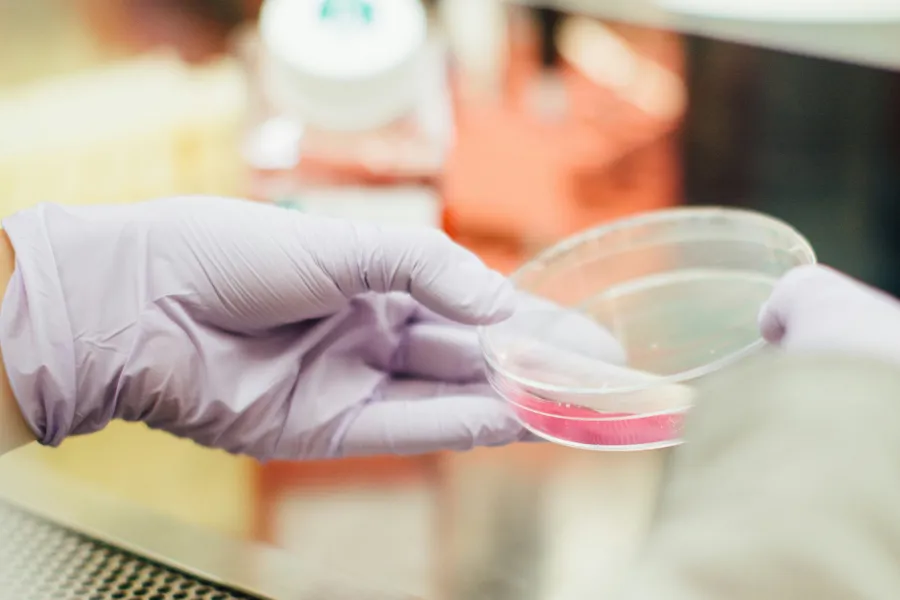
Et nærbilde av en hånd som holder et glass

Nyhet
CAR-T en ny type immunterapi
En kinesisk mann med systemisk sklerose ble en av de første i verden til å få en ny type immunterapi. Forskerne bak studien tror CAR-T-behandling nå vil kunne bli hyllevare for folk med autoimmun sykdom. Det er kanskje å ta i, sier norsk forsker.
Foto: Drew Hays on Unsplash
Les hele saken hos forskning.no
En kinesisk mann med systemisk sklerose ble en av de første i verden til å få en ny type immunterapi
Sist oppdatert 12.11.2024